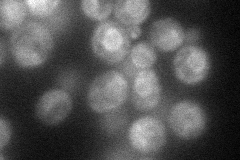
YJR015W
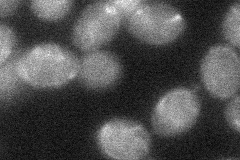
YJR015W
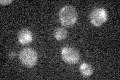
YJR015W

View description
Putative protein of unknown function; localizes to the endoplasmic reticulum and cytoplasm; predicted to encode a membrane transporter based on phylogenetic analysis; YJR015W is a non-essential gene
Localization:
Intensity:
Fold change:
Significance:
-
C’ GFP library in SD

ER18.88 -
N' NOP1pr-GFP in SD
ER58.3694 -
N' TEF2pr-mCherry in SD

ER25.2899 -
N' NATIVEpr-GFP in SD

below threshold17.9185 -
N' TEF2pr-VC and Cyto-VN in SD
below threshold28.6832 -
C’ GFP library in SD+DTT

ER19.41.02No -
C’ GFP library in SD+H2O2
ER17.360.91No -
C’ GFP library in Starvation Media

ER15.990.84No -
C’ GFP library on the background of Pup2-DaMP

ER -
C’ GFP library on the background of CCT mutant

ER16.58360.877891No
